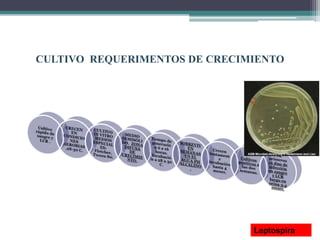
CULTIVO REQUERIMENTOS DE CRECIMIENTO
Leptospira

Borrelia es una bacteria espiroqueta que causa la enfermedad de Lyme. Se transmite a través de la picadura de garrapatas infectadas. Los síntomas incluyen erupciones cutáneas, fatiga, dolores musculares y articulares, y si no se trata puede propagarse a los órganos y causar daños. Leptospira es una bacteria espiroqueta que causa leptospirosis. Se transmite por contacto con la orina de animales infectados. Los síntomas incluyen fiebre, dolor muscular, ic